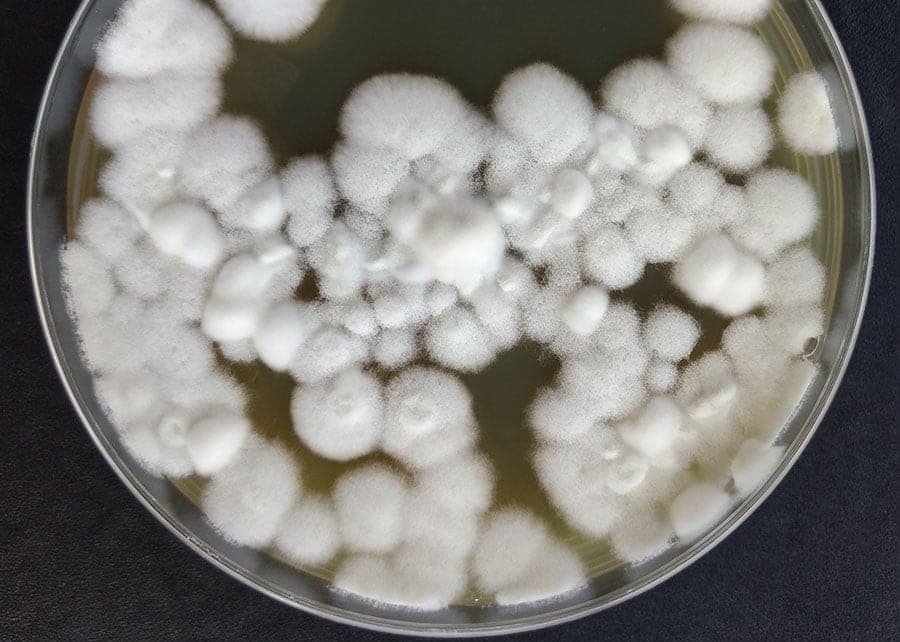

Edição genética cria fungo superpoderoso contra pragas agrícolas
Cientistas brasileiros e americanos avançam na criação de bioinseticidas mais potentes e sustentáveis a partir do fungo Beauveria bassiana. Um estudo recente mostrou que a edição genética de alta precisão, utilizando a tecnologia CRISPR-Cas9 (leia mais abaixo), pode aumentar a eficácia desse organismo no combate a pragas agrícolas.
A pesquisa demonstrou que a modificação de um gene específico – o Bbsmr1 – impulsiona a capacidade do fungo de eliminar insetos com mais rapidez e eficiência.
Segundo Gabriel Mascarin, pesquisador da Embrapa Meio Ambiente (SP), a versão inicial do fungo editado é transgênica, pois contém um gene de resistência. No entanto, as próximas fases da pesquisa pretendem utilizar a edição genética sem inserção de DNA de outras espécies, tornando os fungos não-transgênicos.
Essa abordagem deve acelerar a aprovação regulatória e a comercialização dos novos bioinseticidas no Brasil.
Bioinseticidas mais eficazes e de rápida ação
No estudo, os pesquisadores compararam a eficácia dos blastosporos – células semelhantes a leveduras – com os conídios aéreos, que são amplamente usados nos bioinseticidas comerciais. Os resultados foram surpreendentes: os blastosporos foram 3,3 vezes mais letais e agiram 22% mais rápido do que os conídios.
Nos testes, os blastosporos conseguiram eliminar 97% das larvas da traça-da-cera (Galleria mellonella) em apenas cinco dias, enquanto os conídios mataram apenas 29,4% no mesmo período.
Além disso, a produção dos blastosporos se mostrou mais eficiente, levando apenas dois a três dias em cultivo líquido, enquanto os conídios exigem mais de dez dias em cultivo sólido. Essa vantagem pode facilitar a produção em larga escala e reduzir os custos de bioinseticidas.
Mutação genética aumenta eficácia do fungo
A modificação do gene Bbsmr1 gerou um impacto significativo na performance do fungo, de acordo com a Embrapa. Os mutantes desse gene causaram 50% de mortalidade em insetos em apenas três dias, mesmo em baixas concentrações.
Além disso, essas linhagens demonstraram germinação mais rápida na cutícula dos insetos, maior crescimento na corrente sanguínea das pragas e produção elevada de oosporina, uma substância que enfraquece o sistema imunológico dos insetos.
A oosporina, além de atuar contra insetos, também possui propriedades antifúngicas e antibacterianas, podendo ser utilizada no controle de doenças agrícolas como o mal-do-panamá em bananeiras, a fusariose na alface e a murcha-de-fusarium no tomateiro.
O que é a CRISPR-Cas9
De acordo com a Embrapa, o sistema CRISPR é uma tecnologia que funciona como uma “tesoura molecular”. Por meio dele, a proteína Cas9, guiada por uma sequência de RNA, corta o DNA em locais específicos, permitindo a modificação ou correção de genes.
Dessa forma, é possível otimizar a produção de enzimas, metabólitos e biopesticidas, além de criar microrganismos mais resistentes e funcionais para aplicações sustentáveis.
O alto grau de especificidade e a versatilidade da tecnologia permitem acelerar o desenvolvimento de soluções inovadoras, tornando a engenharia genética microbiana mais acessível e poderosa, informa a Embrapa.
Tecnologia de ponta e desafios a serem superados
A tecnologia CRISPR-Cas9, aplicada no estudo, permitiu realizar alterações genéticas com precisão extrema, sem mutações indesejadas. Isso garante a segurança da técnica e aumenta as chances de aprovação regulatória.
Apesar dos avanços, os cientistas ainda enfrentam desafios. Algumas linhagens editadas apresentaram menor resistência a estresses químicos e produziram menos conídios em determinadas condições. No entanto, os pesquisadores acreditam que a seleção de mutantes pode eliminar esses efeitos colaterais sem comprometer a eficácia da tecnologia.
A pesquisa abre um novo caminho para o desenvolvimento de fungos entomopatogênicos melhorados, permitindo um controle biológico mais eficiente e sustentável. Com o avanço da biotecnologia, o setor agrícola poderá reduzir a dependência de pesticidas químicos, garantindo maior segurança alimentar e preservação ambiental.